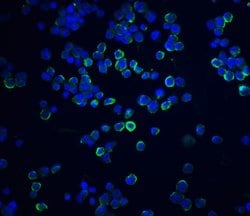
Invitrogen XBP1 Polyclonal Antibody 100 &mu;g; Unconjugated:Anticorps,
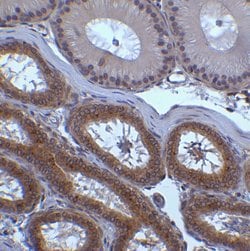
Invitrogen XBP1 Polyclonal Antibody 100 &mu;g; Unconjugated:Anticorps,

missing translation for 'onlineSavingsMsg'
Learn More
Learn More
Invitrogen™ XBP1 Polyclonal Antibody


Rabbit Polyclonal Antibody
Marque: Invitrogen™ PA520218
Les retours ne sont pas autorisés pour ce produit.
Afficher la politique du retour.
Description
A suggested positive control is HepG2 cell lysate. PA5-20218 can be used with blocking peptide PEP-0351.
XBP1 encodes a transcription factor that regulates MHC class II genes by binding to a promoter element referred to as an X box. This gene product is a bZIP protein, which was also identified as a cellular transcription factor that binds to an enhancer in the promoter of the T cell leukemia virus type 1 promoter. It may increase expression of viral proteins by acting as the DNA binding partner of a viral transactivator. It has been found that upon accumulation of unfolded proteins in the endoplasmic reticulum (ER), the mRNA of this gene is processed to an active form by an unconventional splicing mechanism that is mediated by the endonuclease inositol-requiring enzyme 1 (IRE1). The resulting loss of 26 nt from the spliced mRNA causes a frame-shift and an isoform XBP1(S), which is the functionally active transcription factor. The isoform encoded by the unspliced mRNA, XBP1(U), is constitutively expressed, and thought to function as a negative feedback regulator of XBP1(S), which shuts off transcription of target genes during the recovery phase of ER stress. A pseudogene of XBP1 has been identified and localized to chromosome 5.
Spécification
| XBP1 | |
| Polyclonal | |
| Unconjugated | |
| Xbp1 | |
| D11Ertd39e; Hepatocarcinogenesis-related transcription factor; HTF; OTTHUMP00000028682; Tax-responsive element-binding protein 5; tax-responsive element-binding protein 5 homolog; TREB5; TREB-5; X-box binding protein 1; X-box-binding protein 1; X-box-binding protein 1, cytoplasmic form; X-box-binding protein 1, luminal form; XBP1; XBP-1; XBP2 | |
| Rabbit | |
| Antigen affinity chromatography | |
| RUO | |
| 22433, 7494 | |
| Maintain refrigerated at 2°C to 8°C for up to 3 months. For long term storage store at -20°C | |
| Liquid |
| Immunohistochemistry (Paraffin), Immunohistochemistry (PFA fixed), Western Blot, Immunocytochemistry | |
| 1 mg/mL | |
| PBS with 0.02% sodium azide | |
| O35426, P17861 | |
| Xbp1 | |
| A peptide corresponding to 17 amino acids near the amino terminus of human XBP-1. Amino acid range: 40-90. | |
| 100 μg | |
| Primary | |
| Human, Mouse | |
| Antibody | |
| IgG |
Correction du contenu d'un produit
Veuillez fournir vos retours sur le contenu du produit en remplissant le formulaire ci-dessous.
Nom du produit
Vous avez repéré une opportunité d'amélioration ?Partager une correction de contenu